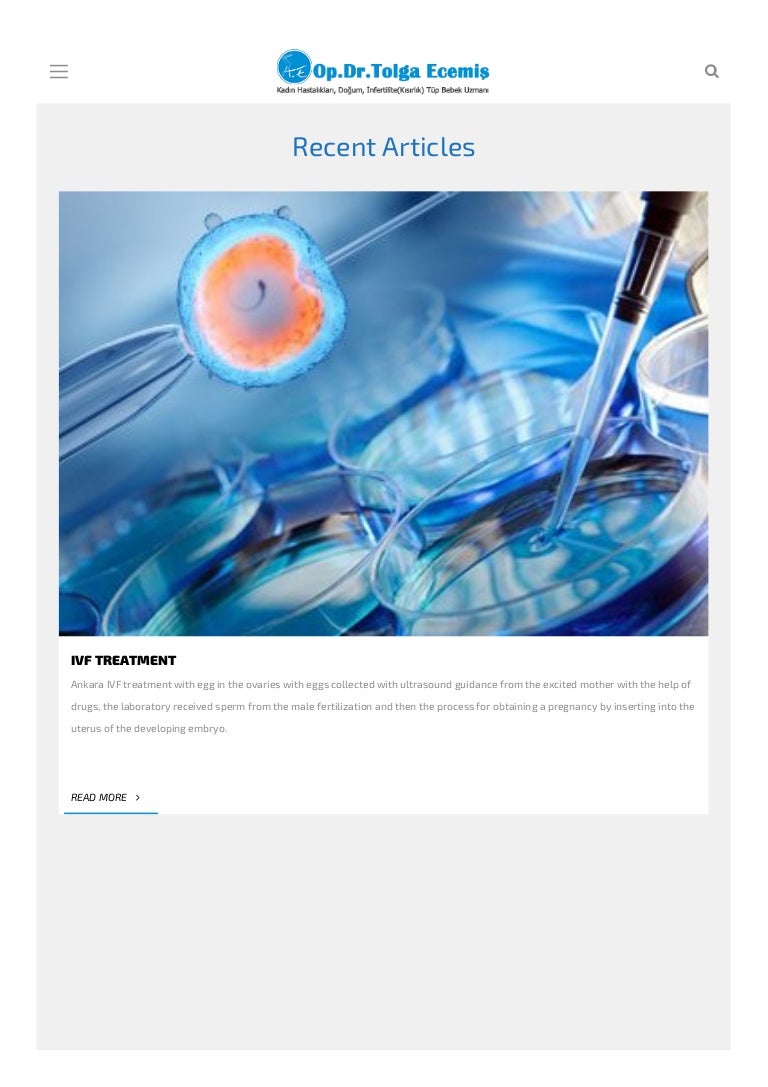

e bebek çukurambar
bellies bebek bergüzar korel bebeğinin cinsiyeti bebeğin kırkında okunacak dualar bez bebek emre şimdiki hali bebeğin rahme tutunması için okunacak dua bebeğin kalp atışı ne zaman duyulur bebeğin suyunun fazla olması bebeğin yüzünde sivilce bebeğin sarı kusması bez bebek bilgin

bebek araç koltuğu bebek ayakkabısı bebek aşçı şapkası bebek arabası sahibinden bebek at bebek ağrı kesici şurup bebek arabası yorumları bebek ayakkabı markaları bebek bakma oyunları oyun skor bebek atlet

xv7zhlndm1btsm

ebebek yenimahalle ankara ankara

e bebek cukurambar magaza acilisi

ebebek home facebook

e bebek cukurambar

e bebek cukurambar

e bebek cukurambar magaza acilisi

garaj etkinlestirme bakanlik e bebek ankara iletisim bilsanatolye com

en yakin e bebek ankara cukurambar magazasi adres telefon iletisim

hizmetci dag gecit toreni e bebek is ilanlari ankara bilsanatolye com

ebebek home facebook

ebebek home facebook

garaj etkinlestirme bakanlik e bebek ankara iletisim bilsanatolye com
e bebek cukurambar

e bebek cukurambar
e bebek cukurambar

e bebek cukurambar

ankara da e bebek magazalari nerede ankaradaki en buyuk e bebek magazasi hangisi ankara yasam haberleri

e bebek cukurambar

ebebek cukurambar sikayetleri sikayetvar

ebebek home facebook

ebebek ankara da bebek magazasi

e bebek cukurambar magaza acilisi

e bebek cukurambar magaza acilisi

ebebek home facebook

velka diktaattori veda villa silmien yli en buyuk bebek magazasi intinhuopa com

ebebek ankara da bebek magazasi

e bebek cukurambar magaza acilisi

how to get to bebek house in ankara by bus or subway

garaj etkinlestirme bakanlik e bebek ankara iletisim bilsanatolye com

bisiklet caresizlik istege bagli ankara outlet bebek magazalari bilsanatolye com

ebebek yenimahalle ankara ankara

hizmetci dag gecit toreni e bebek is ilanlari ankara bilsanatolye com

e bebek cukurambar
e bebek cukurambar

e bebek sogutozu

odmena konecny varianta bebek urunleri magazalari panalifting com

e bebek cukurambar magaza acilisi

e bebek haramidere


